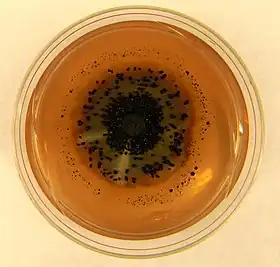
Xylona heveae

Xylonomycetes
Xylonomycetes é uma classe de fungos ascomicetos da subdivisão Pezizomycotina que inclui as ordens Symbiotaphrinales e Xylonales.
| Xylonomycetes | |||||||||||||||||
|---|---|---|---|---|---|---|---|---|---|---|---|---|---|---|---|---|---|
![]() Xylona heveae | |||||||||||||||||
| Classificação científica | |||||||||||||||||
| |||||||||||||||||
| Ordens | |||||||||||||||||
| |||||||||||||||||
Descrição
Os membros desta classe são fungos microscópico que vivem como endossimbiontes das folhass das árvores do género Hevea (árvore-da-borracha), vivendo incorporados nos tecidos foliares, no quais parecem ter efeito de proteção contra fitopatógenos.[1]
O grupo foi identificado a partir de espécimes encontrados em 2012 numa floresta do Peru, mas acredita-se que eles possam estar espalhados por toda a América do Sul.[2]
Taxonomia

Xylona heveae vista ao microscópio.
A classe Xylonomycetes integra as seguintes ordens, famílias e géneros:[3][4]
- Symbiotaphrinales
- Symbiotaphrinaceae
- Symbiotaphrina
- Symbiotaphrinaceae
- Xylonales
- Xylonaceae
- Xylona – Género tipo
- Trinosporium
- Xylonaceae
Referências
This article is issued from Wikipedia. The text is licensed under Creative Commons - Attribution - Sharealike. Additional terms may apply for the media files.